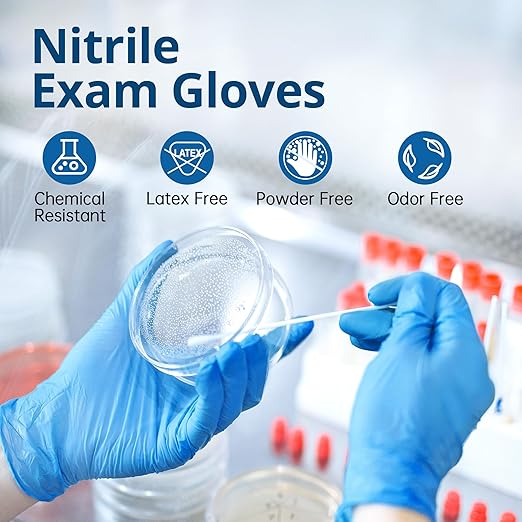

SwiftGrip
Disposable Nitrile Exam Gloves, Blue, Nitrile Gloves Disposable Latex Free, Medical Gloves, Cleaning Gloves, Food-Safe Rubber Gloves, Powder Free, Non-Sterile, 1000-ct Case (X-Small)
Disposable Nitrile Exam Gloves, Blue, Nitrile Gloves Disposable Latex Free, Medical Gloves, Cleaning Gloves, Food-Safe Rubber Gloves, Powder Free, Non-Sterile, 1000-ct Case (X-Small)
Couldn't load pickup availability
About This
- MEDICAL EXAM GLOVES: Our medical grade nitrile gloves passed rigorous medical glove quality tests. Thin but not "cheap", our nitrile gloves provide good tactile sensitivity with reliable hand protection from dirt, oil and organic solvents
- LATEX-FREE: Free of natural latex rubber, these latex-free nitrile gloves reduce allergic skin reactions to latex and protein; these non-latex gloves are stretchy and durable, and more puncture-resistant than similar latex gloves
- FOOD-SAFE: Our powder-free food-grade disposable gloves can be used as food gloves for food processing, food prep, and food handling. As food service gloves they are lightweight and waterproof - an economical solution for frequent glove changes
- SIZE & PACKAGING: Choose from Choose from 50ct, 100ct boxes, or a case of 10 (100ct ea) - 1000 gloves bulk. Case color-coded differently for XS, small, medium, large, and XL sizes. These ambidextrous gloves have a snug fit for men and women
- MULTIPURPOSE: SwiftGrip nitrile gloves offer great dexterity and comfort, ideal for light-duty tasks such as examination, healthcare, household cleaning, food prep, food service, esthetician, salon, and maintenance